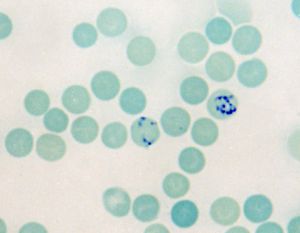
網織紅細胞生成指數

正常值
RPI=1.0。
臨床意義
(1) 溶血性貧血時,若骨髓功能正常:RPI升高3-7倍。 (2) 溶血性貧血時,若骨髓功能受損:RPI上升與貧血程度不一致,只升高<2倍。 (3) RPI降低,而骨髓中含有許多有核紅細胞:有無效紅細胞生成。
注意事項
(1) 近年ICSH和美國國家臨床實驗標準委員會(NCCLS)對網織紅細胞的定義:網織紅細胞是已不含有細胞核,但用新亞甲藍染色法,尚可查見含有相當於核糖核酸的顆粒至少兩個或兩個以上的紅細胞。 (2) 一法復染計數有減低傾向,二法復染使顆粒難以辨別,故網織紅細胞計數以不復染為好。 (3) 網織紅細胞生成指數(RPI),用於校正貧血時幼稚網織紅細胞提前進入末梢血液的假象,網織紅細胞生成指數可為紅細胞生成提供較好的評價指標。正常PRI為1,如貧血患者PRI小於2-3則表示骨髓紅細胞生成低下(表1)。
相關疾病
先天性紅細胞生成異常性貧血,先天性純紅細胞再生障礙性貧血,先天性再生障礙性貧血,急性失血性貧血,老年人巨幼細胞性貧血,鐮狀細胞貧血,再生障礙性貧血
相關症狀
貧血,脾腫大,噁心與嘔吐,皮膚硬化,鼻出血